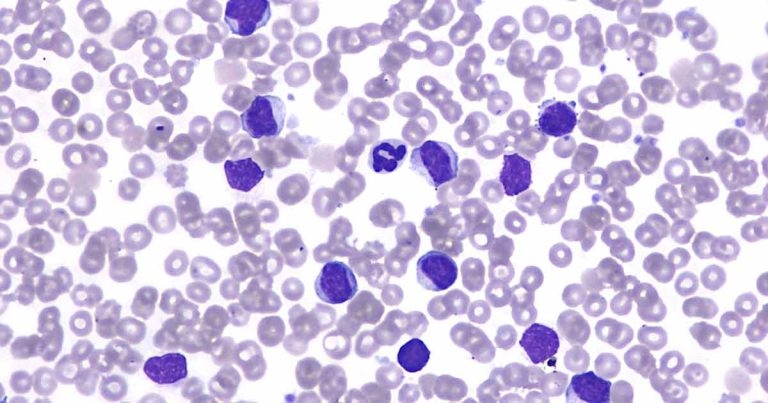
Dog with peripheral leukocytosis

22 Apr 2019
Francesco Cian asks what is the most likely explanation for causing the condition outlined in this latest case from his Haematology Hub.
The images (Wright-Giemsa 50×; Figures 1 and 2) and data (Table 1) are from an ethylenediaminetetraacetic acid blood sample of an adult, mixed-breed, male dog with a clinical history of lethargy and anorexia.
Based on the data and the blood smear pictures, try to answer the following questions.
Evidence exists of a very marked leukocytosis, confirmed on blood smear examination.
The vast majority of the leukocytes seen are intermediate-sized lymphoid cells, characterised by small to moderate amounts of basophilic cytoplasm, occasionally containing fine, pink granules (red arrow).
Nuclei are intermediate in size (approximately 1.5 red blood cell [RBC] to 2 RBC diameter), round, occasionally indented, with granular chromatin and indistinct nucleoli.
The presence of intracytoplasmic pink (also called azurophilic) granules is considered characteristic for large granular lymphocytes (LGLs) – a unique population of lymphoid cells, either T-cell or natural killer (NK) in origin, which normally comprise up to five per cent of the normal peripheral blood lymphocytes.
Identification of LGLs is possible only by blood smear examination at high-power field and cannot rely on analyser-automated cell counts.
Lymphocytosis with LGL can be reactive, generally secondary to infectious disease (for example, Ehrlichia species) and chronic antigenic stimulation, or neoplastic (LGL leukaemia or leukaemic lymphoma). The latter is more likely in this case, especially given the degree of leukocytosis observed.
Full haematology, biochemistry, selected serology testing, extensive clinical investigations and imaging studies are recommended to search for potential inflammatory focus, solid (neoplastic) mass and enlarged organs.
In this case, biochemistry results were unremarkable. The dog was not tested for Ehrlichia species; however, it had not resided in, nor travelled to, a geographic area where the disease was endemic.
Imaging studies identified mild splenomegaly and altered echogenicity. Fine needle aspiration from the spleen revealed large numbers of LGLs, more than expected for a blood contaminated sample – suggesting this being a neoplastic proliferation originating from this organ.
PCR for antigen receptor rearrangements (PARR) performed on the splenic aspirate was positive for a clonal T-cell receptor rearrangement and confirmed the initial suspicion. A diagnosis of LGL chronic lymphocytic leukaemia (LGL-CLL) was made.
LGL-CLL is one of the most common forms of chronic leukaemia in dogs. It often presents as an indolent disease; however, aggressive forms may occur.